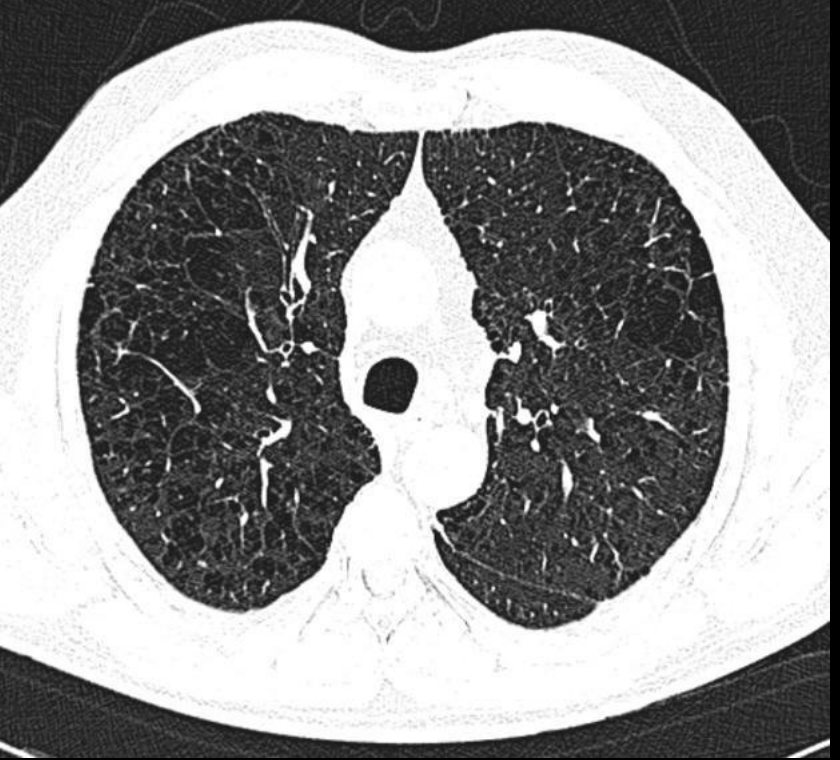

1
Q
Patologías relacionadas
A
Enfisema pulmonar
Bronquitis crónica
2
Q
Aplanamiento del diafragma
Disfunción marcas broncovasculares
Hiperlucidez pulmonar
Corazón en gota
A
Rx enfisema
3
Q

A
Rx enfisema
4
Q

A
Rx enfisema
5
Q
Que imagen distingue distribución en EPOC enfisematoso?
A
TC
6
Q
A
Centrolobulillar
7
Q

A
Paraseptal
8
Q

A
Panlobulillar
9
Q
Rx y TC en bronquitis cronica
A
Patron intersticial
Patrones en tranvia
Engrosámiento peribronquial
10
Q

A
Signo del anillo en bronquitis crónica
11
Q

A
Tranvias y anillos
12
Q

A
Bronquitis crónica


